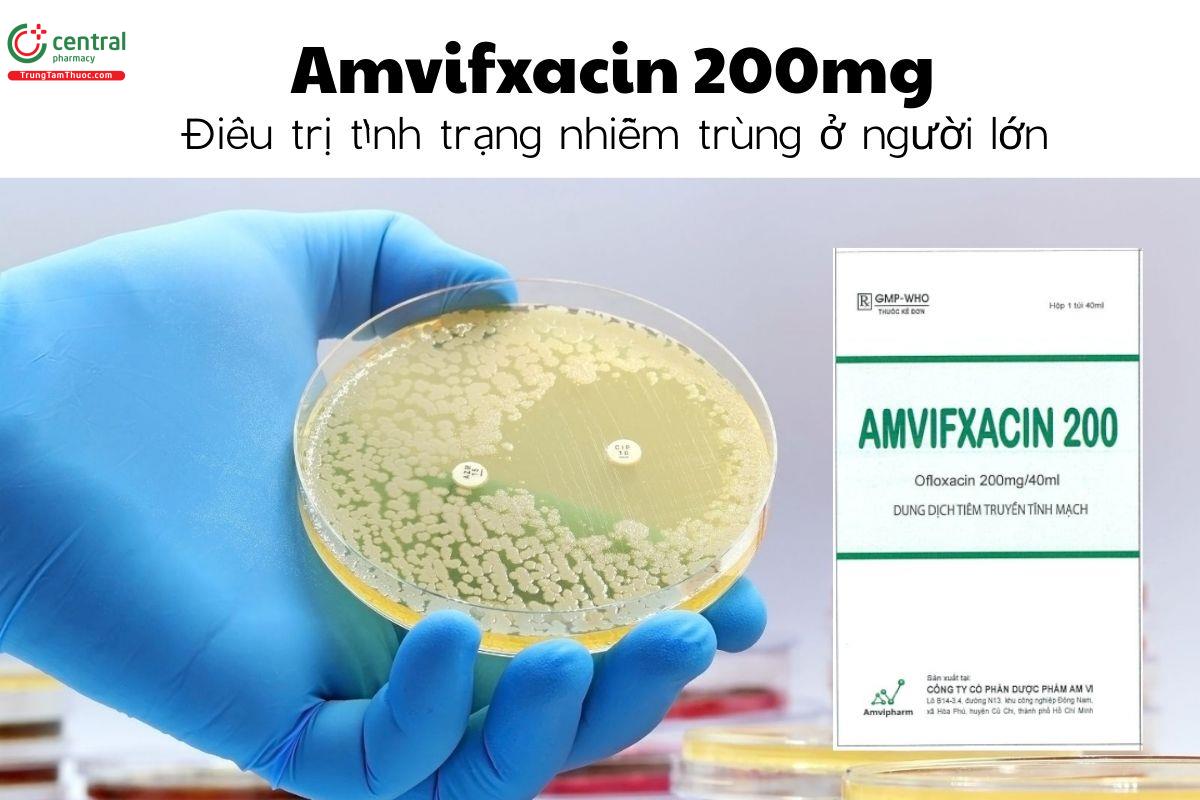
Thuốc Amvifxacin 200mg - Điều trị tình trạng nhiễm trùng ở người lớn

Amvifxacin 200mg
Thuốc kê đơn
Thuốc kê đơn quý khách vui lòng điền thông tin/ chat vào phần liên hệ này để dược sĩ tư vấn và đặt hàng
| Thương hiệu | Amvipharm, Công ty cổ Phần Dược phẩm Am Vi |
| Công ty đăng ký | Công ty cổ Phần Dược phẩm Am Vi |
| Số đăng ký | 893115234125 |
| Dạng bào chế | Dung dịch tiêm truyền tĩnh mạch |
| Quy cách đóng gói | Hộp 1 túi x 40ml |
| Hoạt chất | Ofloxacin |
| Mã sản phẩm | hn547 |
| Chuyên mục | Thuốc Kháng Sinh |
Nếu phát hiện nội dung không chính xác, vui lòng phản hồi thông tin cho chúng tôi tại đây
- Chi tiết sản phẩm
- Hỏi & Đáp 0
- Đánh giá 0
1 Thành phần
Mỗi 40ml Amvifxacin 200mg chứa các thành phần:
Ofloxacin: 200mg
Tá dược: Vừa đủ
Dạng bào chế: Dung dịch tiêm [1]
2 Tác dụng - Chỉ định của thuốc Amvifxacin 200mg
Thuốc Amvifxacin 200mg được dùng cho đối tượng là người trưởng thành, chỉ định điều trị các tình trạng như nhiễm khuẩn tiết niệu phức tạp, nhiễm khuẩn hô hấp dưới, nhiễm khuẩn da và mô mềm, nhiễm khuẩn huyết.
==>> Xem thêm thuốc: Thuốc Ole 200 - Điều trị tình trạng nhiễm trùng do vi khuẩn gây ra
3 Liều dùng - Cách dùng thuốc Amvifxacin 200mg
3.1 Cách dùng
Thuốc Amvifxacin 200mg được sử dụng bằng đường truyền tĩnh mạch.
3.2 Liều dùng
Nhiễm khuẩn tiết niệu phức tạp: 200 mg/ngày. Có thể tăng liều lên 400 mg/lần x 2 lần/ngày nếu bệnh nhân nhiễm khuẩn đường niệu nặng hoặc phức tạp.
Nhiễm khuẩn hô hấp dưới: 200 mg/lần x 2 lần/ngày. 200 mg/ngày. Có thể tăng liều lên 400 mg/lần x 2 lần/ngày nếu bệnh nhân nhiễm khuẩn đường niệu nặng hoặc phức tạp.
Nhiễm khuẩn da và mô mềm: 400 mg/lần x 2 lần/ngày, truyền mỗi 200mg trong ít nhất 30 phút.
Nhiễm khuẩn huyết: 200 mg/lần x 2 lần/ngày. Có thể tăng liều lên 400 mg/lần x 2 lần/ngày nếu bệnh nhân nhiễm khuẩn đường niệu nặng hoặc phức tạp.
Đối với bệnh nhân suy gan, suy thận: điều chỉnh liều tùy thuộc vào tình trạng của từng người.
4 Chống chỉ định
Chống chỉ định dùng Amvifxacin 200mg ở những bệnh nhân có tiền sử quá mẫn với bất kỳ thành phần nào của thuốc.
Bệnh nhân có các tiền sử rối loạn gân cơ liên quan đến sử dụng kháng sinh quilonon hoặc từng bị động kinh hoặc có ngưỡng động kinh thấp.
Bệnh nhân bị thiếu hụt enzym glucose-6-phosphat-dehydrogenase.
5 Tác dụng phụ
Tác dụng phụ thường gặp khi dùng thuốc Amvifxacin 200mg: buồn nôn, nôn, tiêu chảy, nhức đầu, chóng mặt.
Tác dụng phụ hiếm gặp: đau bụng, chán ăn, khó tiêu, lo âu, lẫn lộn, trầm cảm, ảo giác, rối loạn giấc ngủ, rối loạn huyết học, tăng bạch cầu ưa acid, giảm bạch cầu, giảm tiểu cầu.
Tác dụng phụ chưa rõ tần suất: co giật, loạn thần, bệnh lý thần kinh ngoại vi, khó thở, rối loạn chức năng gan, viêm gan, vàng da, hạ huyết áp, viêm mạch,...
6 Tương tác
Thuốc gây kéo dài khoảng QT: Thận trọng khi sử dụng Amvifxacin 200mg ở bệnh nhân đang dùng các thuốc gây kéo dài khoảng QT
Thuốc kháng acid, Sucralfat và các thuốc chứa ion kim loại: Giảm hấp thu của ofloxacin, cần sử dụng ofloxacin trước 2 giờ hoặc sau 6 giờ sử dụng các thuốc trên.
Thuốc chống đông máu nhóm coumarin: Tăng tác dụng chống đông đông máu do đó có thể cần hiệu chỉnh liều thuốc chống đông máu trong thời gian điều trị và sau khi ngừng ofloxacin.
Glibenclamide: cần giám sát chặt chẽ bệnh nhân nếu sử dụng đồng thời với thuốc Amvifxacin 200mg.
Theophylin, fenbufen hoặc các NSAID khác tương tự: Ngưỡng động kinh có thể giảm đáng kể khi phối hợp ofloxacin với các thuốc này do đó xuất hiện động kinh, cần ngừng điều trị bằng ofloxacin.
==>> Xem thêm: Thuốc Thekyflox 200mg - Điều trị nhiễm khuẩn do vi khuẩn nhạy cảm
7 Lưu ý khi sử dụng và bảo quản
7.1 Lưu ý và thận trọng
Bỏ phần dung dịch thuốc Amvifxacin 200mg thừa nếu chưa sử dụng hết. Tuyệt đối không được sử dụng khi dung dịch bị vẩn đục, đổi màu, chứa các phần tử tạp chất có thể nhìn thấy bằng mắt thường, hoặc bao bì thuốc không còn nguyên vẹn.
Thận trọng khi dùng thuốc Amvifxacin cho các đối tượng cần phải làm việc với máy móc hoặc lái xe do thuốc có thể gây chóng mặt và đau đầu.
Trong trường hợp đợt bùng phát nhiễm khuẩn cấp của viêm phế quản mạn và nhiễm khuẩn tiết niệu không phức tạp, chỉ nên sử dụng ofloxacin trong trường hợp không còn lựa chọn điều trị nào khác.
Bệnh nhân không nên tiếp xúc với ánh sáng mặt trời mạnh hoặc tia UV nhân tạo trong thời gian điều trị và trong 48 giờ sau khi ngừng điều trị ofloxacin.
7.2 Lưu ý sử dụng trên phụ nữ mang thai và bà mẹ cho con bú
Chỉ sử dụng thuốc Amvifxacin 200mg cho đối tượng là phụ nữ có thai và cho con bú khi lợi ích điều trị lớn hơn nguy cơ.
7.3 Xử trí khi quá liều
Triệu chứng: lú lẫn, hoa mắt, kém tỉnh táo, ảo giác, run và co giật, kéo dài khoảng QT và một số phản ứng trên tiêu hóa như buồn nôn và trợt niêm mạc tiêu hóa.
Xử trí: Không có thuốc giải độc đặc hiệu khi dùng quá liều thuốc Amvifxacin 200mg, vì vậy cần tiến hành điều trị triệu chứng.
7.4 Bảo quản
Bảo quản thuốc Amvifxacin 200mg ở nơi khô ráo, tránh ánh sáng mặt trời trực tiếp.
8 Sản phẩm thay thế
Trong trường hợp thuốc Amvifxacin hết hàng, quý khách có thể tham khảo các thuốc sau:
- Thuốc Vacoflox 200mg bào chế dạng viên nén bao phim, hộp 3 vỉ x 10 viên, được chỉ định trong điều trị các bệnh nhiễm khuẩn bao gồm: viêm phổi do vi khuẩn nhạy cảm, viêm phế quản tiến triển nặng, bệnh lậu không biến chứng, nhiễm khuẩn đường tiết niệu, viêm đại tràng do vi khuẩn, nhiễm trùng da và mô mềm, ….
- Thuốc Shinpoong Fugacin 200mg bào chế dạng viên nén bao phim, hộp 10 vỉ x 10 viên, được chỉ định trong các trường hợp nhiễm khuẩn như: viêm phế quản nặng, nhiễm khuẩn da và mô mềm, nhiễm khuẩn đường tiết niệu, viêm cổ tử cung do Chlamydia, …
9 Cơ chế tác dụng
9.1 Dược lực học
Ofloxacin ức chế các enzym thiết yếu tham gia vào quá trình sao chép và sửa chữa DNA của vi khuẩn, đặc biệt là DNA gyrase (topoisomerase II) và topoisomerase IV. Khi các enzym này bị ức chế, cấu trúc DNA của vi khuẩn không thể duy trì ổn định, dẫn đến ngừng phân chia và cuối cùng làm vi khuẩn bị tiêu diệt. Nhờ khả năng thấm tốt vào các mô và dịch cơ thể, ofloxacin cho hiệu quả điều trị trong nhiều loại nhiễm khuẩn như nhiễm trùng đường hô hấp, tiết niệu – sinh dục, da và mô mềm.
9.2 Dược động học
Ofloxacin dùng đường tiêm có Sinh khả dụng cao và có khả năng phân bố rộng khắp các mô và dịch trong cơ thể, bao gồm phổi, thận, tuyến tiền liệt, da, mô mềm và dịch tiết đường hô hấp. Hoạt chất Ofloxacin ít bị chuyển hóa trong cơ thể, phần lớn được thải trừ dưới dạng còn hoạt tính. Đường thải trừ chính là qua thận thông qua lọc cầu thận và bài tiết ở ống thận.
10 Thuốc Amvifxacin 200mg giá bao nhiêu?
Thuốc Amvifxacin 200mg hiện nay đang được bán ở nhà thuốc online Trung Tâm Thuốc Central Pharmacy, giá sản phẩm có thể đã được cập nhật ở đầu trang. Hoặc để biết chi tiết về giá sản phẩm cùng các chương trình ưu đãi, bạn có thể liên hệ với dược sĩ đại học của nhà thuốc qua số hotline hoặc nhắn tin trên zalo, facebook.
11 Thuốc Amvifxacin 200mg mua ở đâu?
Thuốc Amvifxacin 200mg mua ở đâu chính hãng, uy tín nhất? Bạn có thể mang đơn mà bác sĩ có kê thuốc Amvifxacin 200mg để mua thuốc trực tiếp tại nhà thuốc Trung Tâm Thuốc Central Pharmacy tại địa chỉ: 85 Vũ Trọng Phụng, Thanh Xuân. Hoặc liên hệ qua số hotline/ nhắn tin trên website để được tư vấn sử dụng thuốc đúng cách.
12 Ưu điểm
- Amvifxacin 200mg chứa hoạt chất Ofloxacin có phổ kháng khuẩn rộng, hiệu quả trên nhiều vi khuẩn Gram âm, Gram dương và vi khuẩn không điển hình, giúp điều trị đa dạng các loại nhiễm khuẩn.
- Thuốc được sử dụng theo đường tiêm truyền nên cho tác dụng nhanh và sinh khả dụng cao, khả năng phân bố tốt vào các cơ quan và mô như phổi, thận, đường tiết niệu,...
13 Nhược điểm
- Amvifxacin 200mg có thể gây ra một số tác dụng phụ không mong muốn như buồn nôn, tiêu chảy, đau đầu, chóng mặt,...
Tổng 9 hình ảnh










